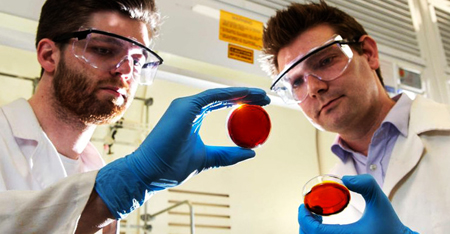
Phát hiện mới về vỏ cam có thể cứu mạng người

Sau thương vụ thâu tóm công ty sản xuất xe điện 2 bánh tự cân bằng Segway vào tháng 4 vừa qua, Xiaomi đã chính thức tung ra phiên bản xe điện mới với mức giá khá mềm, chỉ 315 USD (khoảng gần 7 triệu đồng).
Sau thương vụ thâu tóm công ty sản xuất xe điện 2 bánh tự cân bằng Segway vào tháng 4 vừa qua, Xiaomi đã chính thức tung ra phiên bản xe điện mới với mức giá khá mềm, chỉ 315 USD (khoảng gần 7 triệu đồng).
![]() |
Với Ninebot Mini, về cơ chế, nó hoạt động tương tự như chiếc Segway trước đó với cơ chế tự cân bằng nhờ hệ thống máy tính, động cơ, con quay hồi chuyển và 2 bánh xe lớn.
![]() |
Ở phiên bản này, Xiaomi dùng hợp kim magie để làm khung xe, đi cùng đó là lớp cao su để bọc ván trượt và giá đỡ chống mỏi được thiết kế nhỏ gọn, ngang tầm đầu gối của người dùng. Đây cũng là điểm khác biệt nhiều so với chiếc Segway trước đó, có giá đỡ chống mỏi cao tới tầm tay người dùng.
![]() |
Theo nhà sản xuất cho biết, Ninebot Mini có trọng lượng 12,8 kg, có thể tháo lắp và sắp xếp gọn gàng vào ô tô để có thể mang đi xa. Trong thiết kế của xe, Xiaomi trang bị cho 2 cụm đèn LED phát sáng tạo điểm nhấn và giúp phát sáng khi trong điều kiện tối an toàn hơn.
![]() |
![]() |
Ninebot Mini có thể đi với vận tốc 16 km/h và có thể leo dốc tối đa ở 15 độ. Sau mỗi lần sạc pin, xe điện này cho phép người dùng đi ở quãng đường 22 km.
![]() |
Xiaomi cũng tích hợp cho Ninebot Mini khả năng kết nối với smartphone qua một ứng dụng do hãng cung cấp. Ứng dụng này cho phép người dùng có thể kiểm soát chiếc xe, khóa xe và cảnh báo việc xe đang di chuyển khi đang ở chế độ khóa... Đồng thời, người dùng cũng có thể nâng cấp phần mềm mới cho máy và xem tốc độ xe, tình hình giao thông...
![]() |
![]() |
![]() |
Hiện theo nhà sản xuất cho biết, chiếc xe này sẽ bán ra thị trường Trung Quốc vào ngày 3/11 tới đây. Lộ trình phát hành sản phẩm ở các thị trường khác vẫn chưa được công bố.
Theo dantri